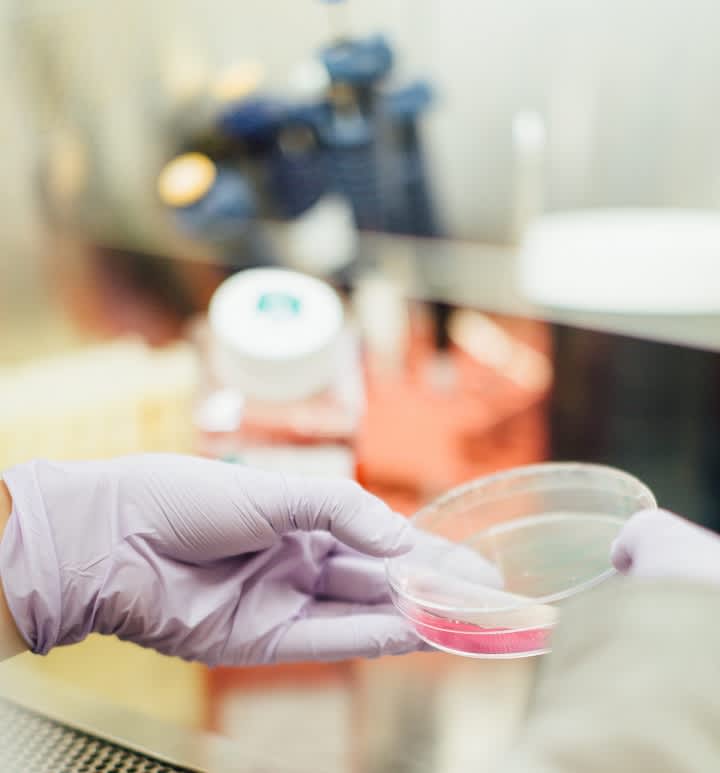
Chemistry_drew - 海斯-206414

University of the South Pacific USP
本科化学
Suva, 斐濟
理学学士
期间
3 年
语言
英语
步伐
全职
报名截止日期
最早开始日期
学费
FJD 18,000 / per year
学习形式
在校园
科学学士学位是一个为期三年的课程,包括二十四门课程;其中八门课程为100级,八门课程为200级,八门课程为三百级。 2017年获得理学学士学位的学科是:
化学学士学位
化学是中心科学。 技术发展的各个方面都需要具有化学专业知识的人才。 医生,牙医,工程师,农民,林业员,工厂经理等都要求进行基础化学教育。 因此,该地区仍然需要化学教师。 此外,作为质量控制人员,生产经理以及一系列政府和私人研究实验室,如矿产勘探,环境污染监测,农业等方面,对工业化学背景的毕业生的需求日益增加。 化学毕业生对区域发展的贡献相当可观。
USP课程化学教学涵盖了100,200,300和研究生水平的课程。 100级和200级课程为现代化学的重要方面提供了基础框架 - 原子和分子结构,热力学,动力学,电化学,无机,光谱学,有机化学中的结构和机理。 然后,这种“基本”知识在300年代被应用于具有重要区域重要性的主题 - 工具分析,工业化学,环境化学和海洋化学。 这样,学生就可以清楚地看到化学原理在周围的世界如何重要。
研究生(400级)课程结合了对区域重要性的基本原则的应用的延伸,对本科课程(如土壤,食品和水分化学)中没有详细介绍的一些化学基本方面进行更先进的处理,天然产物化学,生物化学,聚合物化学和色谱和光谱学的最新进展。
